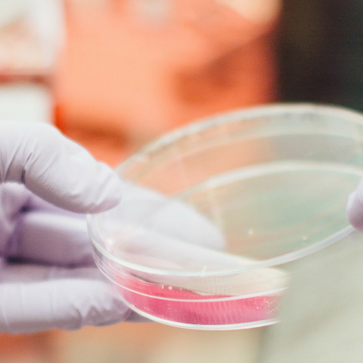

In my 20-plus year career as an investor and investment analyst, I’ve covered every single sector of the market.
I’ve combed through thousands of institutional research reports that large investment firms – like Goldman Sachs, Morgan Stanley, and JPMorgan – publish.
They pay their analysts salaries in the high six-figures to write these research papers. They include traditional financial metrics like discounted cash flow models, earnings estimates, and price targets. They also usually offer ratings like buy, sell, or hold.
But after learning the hard way, several times over again, I’ve realized most of this material is unreliable.
I’ve seen bad calls in the homebuilding sector… the steel sector… the mining sector… and the retail sector. But in my varied experience, I can tell you that one sector produces more poorly timed calls from Wall Street than any other.
That sector is biotechnology.
Risks aside, biotech is poised to be one of the greatest growth industries of the next 50 years. From 2012 to present (November 2017), biotech stocks have outperformed the S&P 500 by almost 100%. And as technological innovation grows exponentially, medical breakthroughs and drug discoveries will only continue.
Very few sectors present the opportunity to invest in companies that can yield life-changing results, literally.
When things work out, not only can you make a fortune, but in some small way, you’ve been involved in the development of a desperately needed therapy or medicine.
It’s surely a difficult market to ignore.
But I can tell you with absolute certainty… most people lose their shirt buying biotech stocks.
Like the precious metals and resource market, biotechnology is an extremely risky sector – flooded with the most volatile investments you can ever make.
Sure, the rewards can be great… If you buy shares of a small biotech stock and its drug gets FDA approval, you’re sitting on a small fortune.
But here’s the story most investors don’t hear: Almost all experimental drugs will never get FDA approval.
It’s why picking biotech losers is far easier than finding a single winner.
Let me explain…
Before reaching any pharmacy shelf, a new drug must pass through a regulatory gauntlet.
These are clinical trials, known as Phases I, II, & III, hosted by the U.S. Food and Drug Administration (FDA). For experimental drug companies, this is a costly process that can last several years.
Which brings me to the most important thing investors need to know about the industry…
The FDA, single handedly, controls the fate of any new drug, treatment, or medical discovery.
More importantly, whenever the FDA raises an eyebrow, speaks, or makes any decision… share prices explode. And often for the worse…
Approximately 70% of drugs get past the initial Phase I. But after that, only 33% of drugs on average succeed past Phase II. Once a drug reaches the most pivotal stage, Phase III, it has only a 25% chance of reaching final FDA review.
As you can see in the graph below, approximately 70% of all drugs in Phase II trials will fail… and so will over 40% of drugs in Phase III.
And even when candidates pass clinical trials, nothing guarantees the FDA will give them its seal of approval.
At the end of the day, less than 10% of ALL drugs that enter clinical trials will receive final FDA approval.
There are hundreds of biotech companies in the U.S. with numerous drugs in their pipelines. Yet in 2016, the FDA cleared just 22 new medicines for sale – a six-year low.
And even then, most of these drugs will fail to achieve blockbuster status or reach over $1 billion in sales.
As you can see, the odds are stacked heavily against investors hoping to partake in the “next big drug” advancement.
So… after years of skepticism, analysis, and investing in this turbulent industry, I’ve had to nail down a strict trading criteria.
Every analyst has his share of winners and losers. But this formula has worked for me time and again…
It’s a set of rules that will not only protects you from the massive volatility in this sector… but can help you safely pocket 300%-plus returns along the way, without getting lucky.
The Low-Risk Biotech Rulebook
Trying to guess which drugs will succeed and whose stock will benefit the most is both troublesome and lucrative. But checking the core necessities of any biotech firm can be just as vital.
Every biotech stock, even before it makes it into my shortlist of potential recommendations, must follow the following criteria:
Rule #1: Money in the Bank
The first rule is to look for biotech firms that have enough money to fund their research programs. The only ways to protect R&D is get either massive amounts of private funding, seal a big pharma acquisition deal, or have enough money in the bank already to survive the lengthy process ahead.
Many investors think that biotech companies have massive R&D operations. But surprisingly, this isn’t the case. True small-cap biotech firms are based on technologies and findings developed at universities. And without the proper funding, the drugs will have an extremely difficult time gaining traction.
Rule #2: Strong Pipelines
Any experienced investor will advise not to put “all of your eggs in one basket.” Well, the same is true even when it comes to biotech…
I look for companies that have a strong drug pipeline so their future isn’t tied to only a specific drug or condition. A private research firm I used to work for called this the “multiple shots on goal” model.
The more shots on goal, the better chance you have of scoring. In biotech terms, the more drugs a company has in its pipeline, the better its chance of eventually getting an FDA approval. This creates a completely new layer of safety for your investment.
I only invest in biotech companies with at least two drugs in their pipeline. It’s critical you do the same and ignore the other “one-trick ponies.”
Rule #3: Partnerships
Here we’re looking for biotech stocks with drug programs that are funded through partnerships with the world’s largest pharmaceutical companies. It’s like having Warren Buffett invest in your start-up… You have a partner with deep pockets, a great list of contacts, and extensive knowledge of the industry.
Rule #4: Management, Management, Management…
Finding the right group of entrepreneurs and executives around the table in biotech is a completely different ball game than most…
These are companies driven by science. To overcome FDA approval, management needs scientific officers that can deeply root and understand the fundamentals of a drug’s capabilities. From mishandling or rushing clinical trials… to choosing the wrong patients or distorting clinical results… to inexperienced management, at all levels, can easily botch a perfectly useful drug.
We want to evaluate companies that not only have hands-on experience, but are lead by management teams that have successfully brought a drug into the market.
Ideally, management also has “skin in the game” – they own a portion of the company, so their incentives are in line with shareholders’.
Rule #5: Never Fall in Love
Behind every stock is a company. And behind every company is a story. Biotech stories are often about misfortune and hope; about individuals whose lives will be vastly improved by new technologies.
“Feel good” investments in drugs that could cure horrible diseases are extremely difficult to ignore. Especially when they offer such huge potential returns.
On my Wall Street Unplugged podcast, we’ve covered some amazing technology stories over the past few years, including immunotherapy (using your immune system to fight off diseases)… DNA sequencing (the ability to test and analyze DNA using simple cost-effective blood tests)… and precision medicine (the death of “one-size fits all” treatment). These are all exciting micro-sectors with the industry’s highest growth potential.
Keep these trends on your radar – but don’t fall in love with a story. Given the chances of any drug reaching the market, every biotech purchase must be considered as an investment – not an act of charity.
Carefully consider today’s lessons before you make a purchase…
Good investing,
Frank Curzio